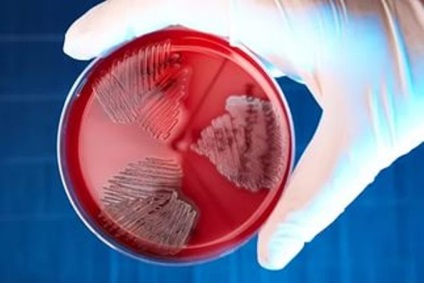

Pseudomonas aeruginosa - o bacterie deosebit de patogene, care pot obține cu ușurință tratamentul în spital; transmiterea sa în casă este posibilă, dar acest lucru se întâmplă foarte rar.
Cele mai frecvente Microbul „trăiește“ în unitățile de terapie intensivă, deoarece acestea au o cantitate mare de echipamente și instrumente utilizate în mod repetat. În același timp, la multe antiseptice, nu este sensibil, iar unele, cum ar fi rivanol, folosește „alimente.“ Creditat cu bacterii și o „inteligență colectivă“.
Esența poveștii de Pseudomonas aeruginosa și bolile pe care le cauzează - nu te trata sau pentru a merge la spital (deoarece concentrația este mai mare în pereții spitalului, decât pe stradă sau acasă). Ideea este de a face tot ce este posibil pentru a bolii nu au necesitat terapie intensiva (sunt oameni care insistă pe un tratament in unitatea de terapie intensiva). Acest concept include o examinare planificată, apel la medic în cazul în care unele simptome obscure, precum și - nutriție adecvată, o activitate suficientă și de întreținere - fără fanatism - Puritatea pielii.

Pseudomonas aeruginosa (Pseudomonas aeruginoza) trăiește în mediul înconjurător. Acesta poate fi găsit: pe teren; pe plante; în aer; pe teme: chiuveta, aparate de aer condiționat, umidificatoare, robinete, în lichide la domiciliu - într-o cantitate mică. De asemenea, urme de volume (minim) de microbi pot fi găsite ca o parte a microflorei normale a axile pielii, pliurile inghinale langa nas sau ureche. Bacteria se comportă în mod pașnic ca imunitatea locală a omului (pH pielea lui, nivelul de imunoglobulină A în epidermă sale, proprietățile bactericide ale salivă, conținut rinofaringiană și sucul gastric) și proprietăți protectoare generale ale corpului sunt menținute la un nivel suficient. Dacă oricare dintre parametrii suferă, sau Pseudomonas cade în cantități mari, sau „livrat“ în mediul intern al corpului, se dezvolta o infectie de Pseudomonas aeruginosa. Simptomele sale va depinde de locul în care în corpul germenului a fost. Astfel, acesta poate fi un agent cauzal al encefalitei, cistita, pneumonie, sau osteomielita. Ea este capabil de a se multiplica în intestine, urechea medie, abcese și răni.
Pseudomonas aeruginosa nu pot trăi în absența oxigenului. Din acest motiv este numit obligatorii (adică obligatoriu) aerob. Este un microb gram negativ, care se bazează pe structura culorii sale atunci când anumiți coloranți. bacterii Gram-negative sunt mai mulți agenți patogeni datorită structurii peretelui celulei lor. Ele formează un pic produse toxice ale metabolismului, dar distrugerea celulelor lor imunitar elibera factor intrinsec, localizat anterior membranei, care provoacă otrăvirea corpului și poate cauza un șoc, care este dificil de a vindeca (dezvolta învinge toate organele interne).
Pseudomonas pseudomonas are o dimensiune de 0,5 microni. Este similar cu bagheta, ale cărei capete sunt rotunjite. Există 1 sau mai multe flageli, care nu numai ca ajuta bacteriile să se miște, dar ele sunt factori suplimentari de agresiune. Acest tip de proteină antigen flagelar a fost izolat 60 de specii de alte bacterii decât în proprietățile sale toxigene. Bacteria creste cel mai bine la 37 de grade, dar continuă să existe la temperaturi mai mari - până la 42 ° C Mediu, unde o Pseudomonas aeruginosa - o carne-peptonă, extract de carne agar și agar nutritiv (substanță gelatinoasă), clorura de tsetilperidiniumom saturată.
Deci, dacă materialul de însămânțare prelevate de la pacient (drenaj mucus din rană, urină, lichid cefalorahidian sau sânge) și asupra mediului înconjurător, nu va fi „punctul“ de culoare albastru-verde, aceasta indică faptul că agentul infecțios - și anume Pseudomonas pseudomonas. microbiologi suplimentare studia proprietatile si tipul de bacterii, sensibilitatea la antibiotice a medicului care a primit acest rezultat, era cunoscut, omul poate fi tratat. O astfel de testare microbiologică - inocularea mediilor de cultură - periodic în fiecare dintre departamentele spitalului, pentru a evalua calitatea de sterilizare a instrumentelor și a echipamentelor. În cazul în care detectează însămânțare Pseudomonas, efectuat dezinfecția suplimentară. Este mult mai rentabilă decât tratarea unui om cu o infectie Pseudomonas, astfel încât aceste studii, în special în unitățile de terapie intensivă, anesteziologie și reanimare, într-adevăr a avut loc.
Pseudomonas aeruginosa produce pigmenți: pyocyanin: și anume ea colorează mediul în culoarea albastru-verde; pioverdin: pigment de culoare galben-verzuie, care prezintă fluorescență atunci când este supus la mediu luminii ultraviolete; piorubin - pigment brun. Bacteria este rezistent la multe dezinfectante datorită dezvoltării de enzime specifice, care le despica.

Capabil să-l distrugă numai:
autoclavare (sterilizare cu abur sub presiune ridicată);
peroxid de 3%; soluție 5-10% din cloramină.
Pseudomonas aeruginosa „lovituri“ pe corpul uman, datorită faptului că:
Acesta poate fi deplasat prin intermediul flageli;
produce o toxina ca produs al propriilor sale funcții vitale, adică, înainte de moartea sa;
Ea produce substante care „exploziile“ celule roșii din sânge afectează celulele hepatice, celule albe din sânge sunt omorâte - celulele imunitare care sunt menite să lupte orice infecție;
sintetizeaza substanțe care ucid alți „concurenți“ bakterii- în locul contactului;
„Stick“ la suprafețele și între ele, acoperite de ansamblu „biofilm“ insensibil la antibiotice, antiseptice și dezinfectante.

Deoarece coloniile Pseudomonas trăiesc pe catetere, tuburi endotraheale, echipament respirator și hemodializă; există enzime care vă permit să mergeți pe spațiul intercelular; sintetiza fosfolipaza, care distruge cea mai mare parte a agentului tensioactiv - o substanță prin care lumina nu „stick“ și poate respira; Ea produce enzime care descompun proteinele, deci bacteriile cauzează moartea țesuturilor la locul acumulării acestuia în cantitate suficientă. O altă caracteristică a pseudomonas prin aceea că ea are o mulțime de factori care permit bacteriile nu se descompun sub actiunea antibioticelor. Acestea includ: enzime care scindează antibioticele bactericide de bază, cum ar fi penicilina, ceftriaxon, cefalexin, și altele asemenea; defecte de proteine, închiderea porilor - „lacune“ în peretele celular al bacteriilor; abilitatea microbului de a deduce droguri din cușca lui.
Cel mai adesea, deși Pseudomonas aeruginoza devine din propriul său corp: de la nivelul tractului respirator superior sau intestinului, în cazul în care acesta poate fi normal, în cantități mici. „Share“ Pseudomonas aeruginosa este: o persoană care trăiește în plămâni (în timp ce tuse); Atunci când o persoană suferă de Pseudomonas stomatita (inflamarea mucoasei orale) - atunci alocă Pseudomonas atunci când vorbim sau strănut; bacterii purtătoare (de exemplu, oameni sănătoși), atunci când rotoare sau pseudomonas populează nazofaringe; Atunci când pregătește o masă un om cu răni purulente pe mâini sau părți expuse ale corpului.
Felul principal încă - în timpul manipulării în spital.
Din nou: bacteria poate provoca boli, atunci când ea a venit în număr mare; l „adus“ înapoi în cazul în care ar trebui să fie absolut sterilă; a căzut în piele deteriorată sau mucoaselor, contactul cu mediul extern (buze, nas, conjunctiva, gură, faringe, organe genitale, urinar canal orificiu exterior, anus);
a redus mucoasei imunitate locală sau a pielii;
a redus de apărare al organismului în general.
Microorganismul este mai bine să „fix“, în membranele mucoase, în cazul în care o persoană este obtinerea o parte din doza în nici un fel, atunci mă duc la sauna, piscina sau sauna.

Cine este în grupul cu risc de infecție
Agentul cauzal este deosebit de periculos pentru: mai vechi de 60 de ani;
copiii în primele trei luni de viață;
necesitând hemodializă;
diabetici;
persoanele care au suferit transplanturi de organe;
lung care primesc agenți hormonali (de exemplu, pentru tratamentul artritei reumatoide, lupus sau alte boli sistemice);
au malformații ale sistemului genito-urinar;
bronșită cronică;
forțat șederea prelungită în spital.

De asemenea, este posibil să se prevadă modul în care boala se va dezvolta etiologie Pseudomonas - varsta, boala primara sau de manipulare în curs de desfășurare
Cel mai adesea pacienții suferă de aceste ramuri: terapie intensivă; arde; chirurgicale, în care operațiile sunt efectuate pe abdomen, precum și abcese și furuncule sunt deschise; chirurgie cardiacă. Bolile cauzate de Pseudomonas aeruginosa aeruginoza cauze diverse boli, în funcție de locul în care infecția intră. Conform statisticilor, acesta este agentul cauzal: aproximativ 35% din toate bolile sistemului urinar; aproape un sfert din toate patologiile chirurgicale purulente; 5-10% din totalul pneumoniei comunitare; și 10-35% din aceste inflamații ale țesutului pulmonar, care a dezvoltat în a treia zi sau mai târziu, după admiterea la spital. Noțiuni de bază în orice organism, Pseudomonas aeruginosa trece prin trei etape: Se atașează la țesutul prin care a venit, și apoi începe să se multiplice acolo. Astfel au format scopul principal al infecției. Se întinde de la centrul de primar în minte profund țesut. Absorbția de bacterii, cu toate enzimele sale și toxinele din sânge, și mai mult fluxul de sange pentru Pseudomonas se raspandeste prin restul organelor. Astfel, apariția de celulită a țesutului moale poate în acest stadiu, duce la formarea de pneumonie, pielonefrita, si chiar substanta leziuni ale creierului. Conform uneia dintre semnele doar spun că agentul cauzal - Pseudomonas aeruginosa, este imposibil, deoarece provoacă, cum ar fi infectii ale urechii, pneumonie, gastroenterită, precum si alte bacterii (Klebsiella, Staphylococcus). Bănuiesc acest microb special, poate fi, sau faptul că o persoană a fost recent tratat într-un spital, sau lipsa de eficiență a tratamentului începând cu antibiotice (atunci când numit antibiotice „obișnuite“, iar temperatura continuă să dețină, și hemoleucograma nu se îmbunătățește). Principalele simptome ale infecției cu Pseudomonas este prezentată mai jos semne de boli cauzate de Pseudomonas aeruginosa, când tratamentul cu antibiotice a fost efectuat. În cazul în care persoana care primește tratament, tabloul clinic (de exemplu, simptome), de obicei, lubrifiate exprimate încet.
În cazul în care Pseudomonas „justificat“ în gât, aveți următoarele simptome:
durere în gât, mai rău la înghițire; febră; amigdalele roșii și umflate; buzele crăpate.
În cazul în care infecția cu Pseudomonas se dezvolta in gat, apoi apar: tuse, de obicei uscata, care apare după vreo durere sau disconfort în gât, este îmbunătățită prin adoptarea unei poziții orizontale; febră; slăbiciune; oboseală. În cazul în care agentul cauzator de „stabilit“ in nas, aceasta duce la dezvoltarea unui lung rece, senzație de congestie nazală, scăderea simțului mirosului, dureri de cap periodice (de multe ori - pe de o parte, este mai mult pe frunte).
Pseudomonas aeruginosa în ureche devine cauza otitei externe, care se manifestă: earache; emergență din acestea galben-verzui gros de scurgere de sânge; afectarea auzului;
infectie Pseudomonas a sistemului digestiv
În cazul în care un număr suficient de Pseudomonas sa dovedit in intestin, simptome de infectie se dezvolta gastroenterocolitei.
Acestea sunt:
în primul rând - vărsături mâncat alimente, durere, „stomac“ recent;
durere, apoi se mută la ombilic și devine mai difuză;
apar slăbiciune; pierderea poftei de mâncare;
greață;
temperatura se ridică la un număr mic (până la 38 nu ajunge);
scaune frecvente: până la 7 ori pe zi, Pappy, verzui;
are striuri de sânge și / sau mucus;
toate finisajele în 3-4 zile fără tratament, dar infecția devine cronică (mai rar - transport asimptomatic).
În cazul în care o astfel de stare a dezvoltat o persoană infectată cu HIV, cel care a suferit transplant de organe, cu glucocorticoizi sau au finalizat recent un curs de chimioterapie sau radioterapie tratate cu hormoni, se poate dezvolta Pseudomonas, sepsis gram-negativ.

infectie Pseudomonas a sistemului urinar
Această serie de boli - pielonefrita, cistita, uretrita - care sunt diagnosticate prin prezența Pseudomonas aeruginosa în urină. Astfel de boli nu se dezvoltă la „zero“. Oamenii suferă: cu imunitate redusă; au malformații ale sistemului genito-urinar; care suferă de boli de rinichi de piatra; care au de multe ori la catheterize vezicii urinare (de exemplu, adenom de prostată). Simptomele leziunilor tractului urinar Pseudomonas nu sunt specifice. Este o durere în spate, de tăiere dureri în timpul urinării, durere la urinare, senzație de golirea incompleta a vezicii urinare, o creștere a temperaturii, schimba culoarea și mirosul de urină. Caracterizat prin faptul că, în cursul unei astfel de perioade lungi de boală, atunci când perioadele de mai sus de simptome de exacerbare intercalate cu intervale asimptomatice. De "Norfloxacin", "Monural" sau "5-nitroksolin" nu au nici un efect semnificativ. Deoarece Pseudomonas infecții ale tractului urinar poate dura mai multe luni sau ani.